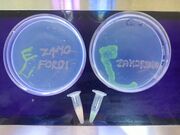

Uploads by Paul R Jaschke
From OpenWetWare
Jump to navigationJump to search
This special page shows all uploaded files.
| Date | Name | Thumbnail | Size | Description |
|---|---|---|---|---|
| 16:52, 25 May 2014 | Copper Biosensor plasmid map.png (file) |  |
89 KB | |
| 16:51, 25 May 2014 | Copper Biosensor plasmid map.pdf (file) | 22 KB | ||
| 16:49, 25 May 2014 | PRJ0044A.jpg (file) |  |
3.13 MB | |
| 16:48, 25 May 2014 | PRJ0044-2.eps (file) | 1.68 MB | ||
| 16:15, 25 May 2014 | Lake Yojoa Honduras.JPG (file) |  |
52 KB | |
| 16:07, 25 May 2014 | 20130607 080518.jpg (file) | |
1.85 MB | |
| 16:04, 25 May 2014 | DSC 0296.JPG (file) |  |
5.52 MB | |
| 16:03, 25 May 2014 | DSC 0161.JPG (file) |  |
4.83 MB | |
| 16:02, 25 May 2014 | DSC 0138.JPG (file) |  |
4.83 MB | |
| 16:02, 25 May 2014 | DSC 0135.JPG (file) |  |
5.68 MB | |
| 15:31, 25 May 2014 | DSC 0244.JPG (file) |  |
5.63 MB | |
| 17:13, 16 June 2013 | Paul Jaschke v-card.vcf (file) | 5 KB | ||
| 17:09, 16 June 2013 | Paul Jaschke June 2013 Resume.pdf (file) | 87 KB | ||
| 17:05, 16 June 2013 | Paul Jaschke June 2013 CV.pdf (file) | 144 KB | ||
| 04:34, 5 April 2013 | PhiX174 1f.gb (file) | 17 KB | ||
| 04:28, 5 April 2013 | PRS425--phiX174 1f.gb (file) | 26 KB | ||
| 04:17, 5 April 2013 | PRS425--øX1741f.gb (file) | 26 KB | ||
| 04:10, 5 April 2013 | PhiX174.gb (file) | 26 KB | ||
| 03:49, 5 April 2013 | IMG 1311.JPG (file) |  |
2.31 MB | |
| 03:47, 5 April 2013 | IMG 1295.JPG (file) |  |
2.53 MB | |
| 05:14, 30 January 2013 | Virology-Phage in Yeast-2012.pdf (file) | 703 KB | ||
| 19:07, 24 January 2013 | SynBERC March 2012.pdf (file) | 1.4 MB | ||
| 18:29, 24 January 2013 | Paul Jaschke PhD.vcf (file) | 25 KB | ||
| 20:30, 22 November 2012 | Pjaschke2.jpg (file) |  |
247 KB | |
| 18:32, 23 October 2012 | 1-s2.0-B9780123850751000238-main.pdf (file) | 409 KB | ||
| 15:19, 21 October 2012 | Paul Jaschke Oct 2012 CV.pdf (file) | 256 KB | ||
| 22:49, 18 October 2012 | 1-s2.0-S0042682212004618-main.pdf (file) | 782 KB | ||
| 22:37, 18 October 2012 | Jp300304r.pdf (file) | 1.84 MB | ||
| 04:34, 11 June 2011 | French Press.png (file) | 109 KB | ||
| 04:13, 11 June 2011 | J. Biol. Chem.-2011-Jaschke-20313-22.pdf (file) | 1.55 MB | ||
| 03:23, 26 May 2011 | Badge Graphic 6-01.png (file) |  |
1.39 MB | |
| 06:03, 25 May 2011 | Bi701407kn00001.gif (file) |  |
54 KB | |
| 05:44, 25 May 2011 | 2010-212605-ver 3-01.png (file) |  |
1.22 MB | |
| 15:55, 21 May 2011 | IMG 7039.JPG (file) |  |
1.81 MB | |
| 15:49, 21 May 2011 | IMG 7037.JPG (file) |  |
2.14 MB | |
| 04:49, 21 May 2011 | IMG 7034.JPG (file) |  |
2.38 MB | |
| 04:48, 21 May 2011 | IMG 7039.jpg (file) |  |
1.81 MB | |
| 04:47, 21 May 2011 | IMG 7037.jpg (file) |  |
2.14 MB | |
| 04:47, 21 May 2011 | IMG 7034.jpg (file) |  |
2.38 MB | |
| 04:45, 21 May 2011 | IMG 7028.JPG (file) |  |
2.8 MB | |
| 04:44, 21 May 2011 | IMG 7026.JPG (file) |  |
3.57 MB | |
| 04:42, 21 May 2011 | IMG 7018.JPG (file) |  |
3.02 MB | |
| 04:40, 21 May 2011 | IMG 7006.JPG (file) |  |
2.98 MB | |
| 04:38, 21 May 2011 | IMG 7011.JPG (file) |  |
3.25 MB | |
| 04:37, 21 May 2011 | IMG 6987.JPG (file) |  |
4.03 MB | |
| 04:35, 21 May 2011 | IMG 6983.JPG (file) |  |
2.75 MB | |
| 04:34, 21 May 2011 | IMG 6982.JPG (file) |  |
4.64 MB | |
| 05:53, 20 May 2011 | IMG 6974.JPG (file) |  |
2.61 MB | |
| 05:46, 20 May 2011 | IMG 7025.JPG (file) |  |
3.73 MB | |
| 05:46, 20 May 2011 | IMG 7021.JPG (file) |  |
2.85 MB |